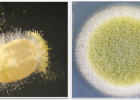

전북뉴스

- 정읍시, 289억 투입해 학교주변 전봇대 뽑는다

- 남원시, 관광상품 개발비 최대 400만원 지원
- 익산시, 인구 10명 전입시키는 시민에 장려금 최대 100만원
- 익산시는 다른지역 인구를 전입시키는 시민에게 최대 100만원의 장려금을 지급할 계획이라고 15일 밝혔다. 올 연말에 다가올 것으로 우려되는 인구 28만명선 붕괴를 막기 위한 종합대책의 하나다. 장려금은 5명 이상...

- 고창모양성제, 주민안전기원 성황제로 연다

- 국제와이즈멘 전북지구, 남원시 수해 주민 위해 1000만원

- 국토부 도시재생 발표대회 군산 우체통거리 ‘최우수’
- 전북, 초미세먼지 발령일 작년 65일…전국 최고
- 지난해 초미세먼지 주의보 발령일수가 전북지역이 17개 시·도 중 가장 많았던 것으로 나타났다. 15일 국회 환경노동위원회 더불어민주당 윤준병 의원(정읍·고창)은 전북지방환경청에 대한 국정감사에서 “지난해 초미세먼지...
- 지난해 초미세먼지 발령일 전북 65일…전국 최고
- 지난해 초미세먼지 주의보 발령일수가 전북지역이 17개 시·도 중 가장 많았던 것으로 나타났다. 15일 국회 환경노동위원회 더불어민주당 윤준병 의원(정읍·고창)은 전북지방환경청에 대한 국정감사에서 “지난해 초미세먼지...

- 여고생이 부른 ‘고창아리랑’ 유튜브 인기

- 군산·익산·순창 ‘소외계층 없는 관광지 조성사업’ 선정

- 새만금 스마트 수변도시 연내 착공

- 고창 월곡근린공원 친환경생태놀이터로 새단장
- 익산시, ‘2020 북페스티벌’ 온라인·드라이브인 방식 운영
- 익산시는 ‘2020 북페시티벌’을 비대면 방식인 ‘온라인·드라이브인’ 방식을 도입, 개최한다고 13일 밝혔다. 북페시티벌은 오는 23~24일 열린다. 이번 행사는 ‘책향기로 탑을 쌓다’를 주제로 펼쳐진다. 행사에서...
- 농업 민원상담 ‘챗봇’ 도입 고창군, 첫 비대면 서비스
- 고창군은 실시간으로 농업 민원상담이 가능한 ‘챗봇’을 전북지역 지자체 최초로 운영한다고 11일 밝혔다. ‘챗봇’은 채팅과 로봇의 합성어로 인공지능 기반의 대화형 메신저이다. 이용자는 카카오톡에 ‘고창군 농생명지원...
- 순창 곰팡이 산업화 성공

- 익산시, 천만송이 국화축제 대체 ‘행복정원’ 조성
오피니언더보기

- 사설
- 상인 불신 ‘복합쇼핑몰 효과’ 설득력 갖추길

- 박진현의 문화카페
- ‘레고산수’가 남긴 것

Copyright © 2016 광주일보. All Rights Reserverd.

